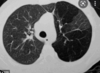
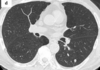

Tele de tórax
Posteroanterior
Tórax óseo
Anteroposterior
Mejor método para evaluar tórax
TC
¿Qué es un patrón pulmonar?
Manifestación de una patología
Tipos de patrones pulmonares
- Alta densidad
- Baja densidad
Patrones pulmonares de alta densidad (5)
- Vidrio de espulido
- Consolidación
- Reticular
- Atelectasia
- Nodular
Patrones pulmonares de baja densidad
- Quiste
- Caverna
- Bulla
- Bronquiectasia
- Mosaico
- Enfisema
- Neumotorax
Patrón de consolidación alveolar
Aumento de la atenuación pulmonar
Estudios de imagen de patrón de consolidación alveolar
Rx - radioopacidad irregular y mal definida
TC - Hiperdensidad irregular y mal definida
Causas del patrón de consolidación alveolar
Ocupación del espacio aéreo alveolar (sangre, pus, agua, exudad)
Más frecuente - Neumonía
Dato clave del patrón de consolidación alveolar
Broncograma aéreo


Consolidación alveolar

Consolidación alveolar

Consolidación alveolar
Patrón intersticial reticular
Opacidades lineales en red o telaraña
Estudios de imagen para patrón intersticial reticular
Rx - líneas finas o gruesas que se ven en los extremos del pulmón
TC - líneas finas o gruesas
Causas de patrón intersticial reticular
Ocupación o enfermedad del intersticio (FQ, edema pulmonar)

Patrón intersticial reticular

Patrón intersticial reticular

Patrón intersticial reticular

Patrón intersticial reticular
Patrón nodular
Frecuente en enfermedades granulomatosas
¿Cuándo se considera nódulo y cuándo masa?
< 3 cm - masa
> 3 cm - nódulo
Posibles diagnósticos de nódulo solitario
+ Cáncer
+ TB
+ Neumonía